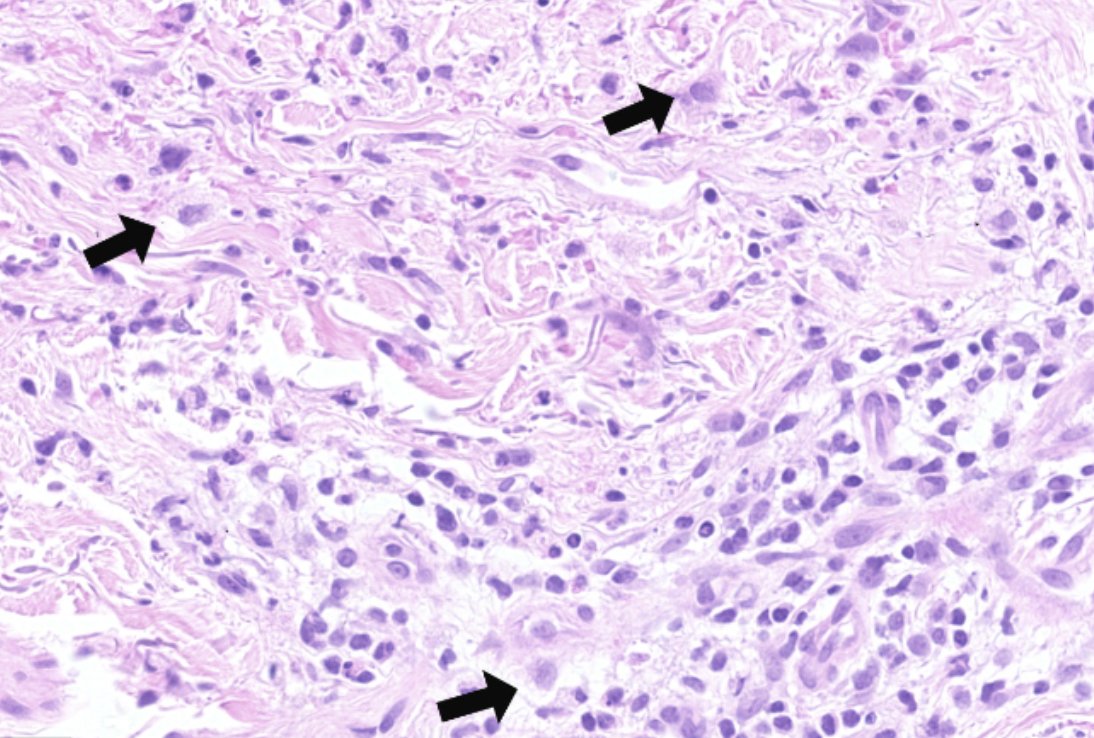

Asma Arshia
@arshi_asma
PGY-4 at the University of Kentucky, Incoming Cytopathology fellow @University of Michigan 25-26๐ฌ
ID: 1262144810082807808
17-05-2020 22:16:00
1,1K Tweet
703 Followers
504 Following



histiocytoid cells with loose, feathery cytoplasm as a clue to what diagnosis? doi.org/10.1111/cup.14โฆ J Cutan Pathol #dermpath #dermatology #pathology

๐ข Attention aspiring cytopathologists!Temple Pathology is now accepting applications for the Fully Accredited Cytopathology Fellowship (2025-2026). ๐ Apply now! ๐ง For inquiries, contact Fellowship Program Director Dr. Israh Akhtar at [email protected]. #cytopath



LIVE: NASA's Johnson Space Center experts discuss two upcoming spacewalks on Jan. 16 and Jan. 23 to work on the International Space Station, including repairs to our NICER X-ray telescope and updates to the Canadarm2 robotic arm. x.com/i/broadcasts/1โฆ


Thyroid nodules with DICER1 mutation or PTEN alteration: A comparative cytologic, clinical, and molecular study of 117 FNA cases acsjournals.onlinelibrary.wiley.com/doi/full/10.10โฆ WC Faquin, MD, PhD Zubair Baloch #CytoPath




๐ฅ#OpenAccess: FNA and effusion cytology of thoracic SMARCA4โdeficient undifferentiated tumor and SMARCA4-deficient NSCLC: A multi-institutional experience with 27 patients acsjournals.onlinelibrary.wiley.com/doi/full/10.10โฆ #CytoPath Liron Pantanowitz Swati Satturwar Sanjay Mukhopadhyay Nicole Zalles MD, PhD




Attending #USCAP2025 in Boston ? Donโt forget to join the Papanicolaou Society Companion Meeting presented by the great speakers on March 23! Details below๐โฌ๏ธ Diagnostic Cytopath International Academy Cytology Aziza Nassar Zubair Baloch


FHRCC cytology shows key features supporting diagnosis. Confirm with FH and 2SC IHC on limited biopsies. acsjournals.onlinelibrary.wiley.com/doi/10.1002/cnโฆ Ali Lowe Patrick Mullane Hubert Lau Xiaohua Qian, MD Stanford Pathology #CytoPath #IHCPath



Reporting live from The Digital Pathology Association with Dr. Bui Pathologist๐ผ & Dr. Lujan to share #digpath #PathX Students, residents, pathologists, join us: digitalpathologyassociation.org Be a part of various committees! Apply today ๐ฌ OhioStatePath Michigan Pathology USCAP


